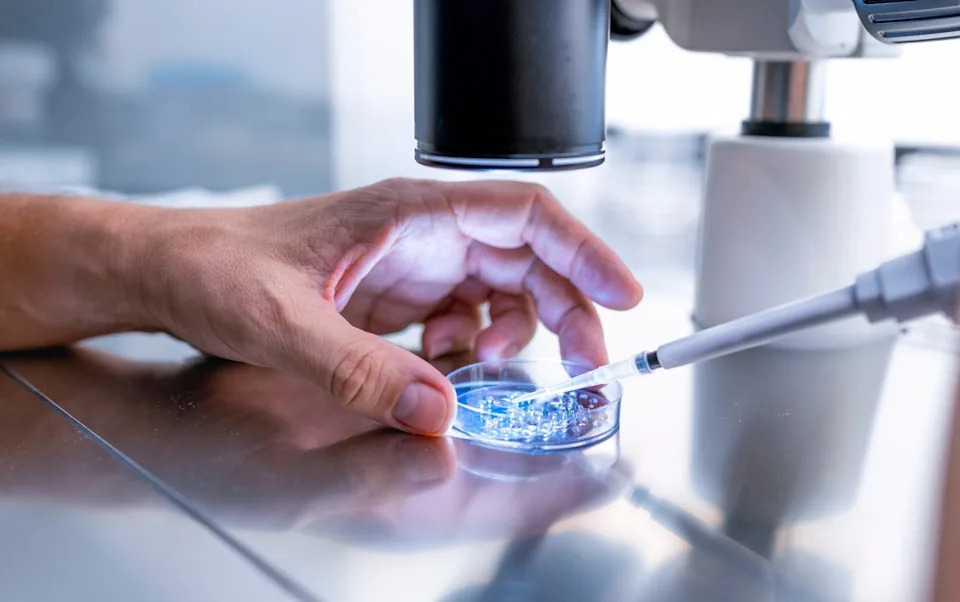
Spermatozoidi Na Poligonu Prepreka: Koliko Je Reprodukcija Moguća U Svemiru?

Australijski tim koristio je minijaturnu plastičnu stazu koja imitira reproduktivni trakt da bi testirao spermatozoide u uslovima simulirane mikrogavitacije. Sposobnost kretanja spermatozoida pala je za oko 50%, što je dovelo do približno 30% manjeg uspeha oplodnje. Međutim, spermatozoidi koji su uspeli dali su embrione boljeg kvaliteta, dok je rani razvoj embriona (prvih 24 sata) bio značajno ugrožen. Istraživači ističu da će zaštita embriona u kritičnim prvim satima verovatno biti ključna za reprodukciju u svemiru.
Spermatozoidi Na Poligonu Prepreka: Koliko Je Reprodukcija Moguća U Svemiru?

Naučnici u Australiji ispitali su koliko bi uslovi nalik svemiru mogli da utiču na sposobnost spermatozoida da „navigiraju“ do jajne ćelije i na rani razvoj embriona. Istraživanje, objavljeno u časopisu Communications Biology, pokazuje da dok neki spermatozoidi uspevaju da prođu prepreke u uslovima simulirane mikrogavitacije, rani embrionski razvoj ostavlja ozbiljna pitanja.
Kako je sprovedeno istraživanje
Tim sa University of Adelaide koristio je minijaturnu plastičnu komoru koja podseća na ženski reproduktivni trakt i predstavlja malu traku sa preprekama kroz koju spermatozoidi moraju da prođu. Komoru su postavili u uređaj koji rotacijom simulira uslove smanjene gravitacije, nakon čega su pratili ponašanje i uspešnost spermatozoida ljudi i miševa, kao i rani razvoj oplođenih jajnih ćelija.
Glavni nalazi
Sposobnost spermatozoida da prođu kroz poligon bila je približno 50% umanjena u simuliranim uslovima mikrogavitacije u poređenju sa Zemljinom gravitacijom. Autori navode da je to rezultovalo otprilike 30% manjim uspehom oplodnje. Zanimljivo, spermatozoidi koji su ipak uspešno prošli kroz stazu često su dali embriogenske stadijume boljeg kvaliteta, što istraživači tumače kao selektivni efekat „stresa“—preživeli spermatozoidi su bili najotporniji i najkvalitetniji.
Nicole McPherson, istraživačica sa University of Adelaide: "Spermatozoidi moraju aktivno da pronađu put do jajne ćelije. Ovo je prvo istraživanje koje tu sposobnost testira u uslovima sličnim svemiru."
Međutim, najveći izazov primećen je u prvih 24 sata nakon oplodnje: formiralo se manje embriona, a oni koji su se formirali bili su lošijeg kvaliteta. To sugeriše da iako mikrogavitacija možda ne onemogućava sam čin oplodnje, zaštita embriona u kritičnim prvim satima nakon oplodnje može biti ključna za uspešnu reprodukciju u svemiru.
Širi kontekst i implikacije
Ovi rezultati su važni za planove o ljudskoj kolonizaciji Meseca i Marsa, kao i za industriju svemirskog turizma. Autori upozoravaju da su potrebna dalja istraživanja kako bi se razumeli dugoročni efekti mikrogavitacije na reprodukciju, razvoju embriona i zdravlje potomstva pre nego što pomislimo na rađanje deteta izvan Zemlje.
Zaključak: Istraživanje pokazuje da je oplodnja u uslovima sličnim svemiru moguća, ali rani embrionski razvoj je ranjiv u odsustvu normalne gravitacije. Dalji rad fokusiraće se na načine zaštite embriona u prvim satima posle oplodnje i na ispitivanje dugoročnih posledica.
Pomozite nam da budemo bolji.




























